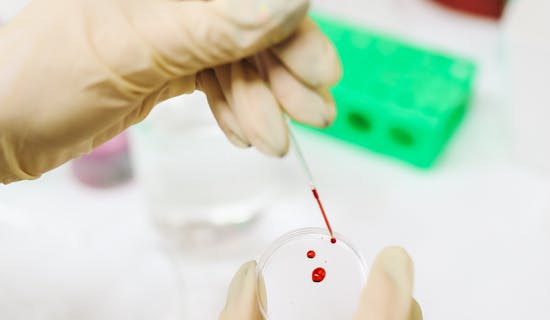
怀孕几个月可以做dna亲子鉴定

随着科技的发展,DNA亲子鉴定成为一种准确、可靠的方法来确认亲子关系。这项技术不仅可以在孩子出生后进行,还可以在怀孕期间进行。但是,许多人都不清楚怀孕几个月可以进行DNA亲子鉴定。
DNA亲子鉴定是通过比对父母和孩子的DNA序列来确认亲子关系的一种技术。每个人的DNA序列都是独一无二的,因此可以通过比对DNA序列来确认亲子关系。DNA亲子鉴定的方法主要有两种:非侵入式和侵入式。非侵入式方法是通过收集母亲的唾液和孩子的唾液样本来进行比对,而侵入式方法则是通过羊水穿刺或脐带血来进行比对。非侵入式方法相对简单和安全,而侵入式方法则需要进行一定的手术操作。
怀孕几个月可以进行DNA亲子鉴定呢?一般来说,非侵入式的DNA亲子鉴定可以在怀孕8周以后进行。这是因为在此时,胎儿的DNA已经开始在母体血液中循环,可以通过母亲的血液样本来进行检测。而侵入式的DNA亲子鉴定一般需要在怀孕14周以后进行,这是因为在此时羊水或脐带血已经足够来进行DNA检测。需要注意的是,进行侵入式的DNA亲子鉴定需要在医生的指导下进行,同时也需要谨慎考虑风险和利益。
在选择进行DNA亲子鉴定时,需要注意以下几点:
1、寻找正规的实验室,确保结果的准确性和可信度。
2、在进行非侵入式的DNA亲子鉴定时,需要收集足够的母亲和孩子的唾液样本,并确保样本完整和干燥。
3、在进行侵入式的DNA亲子鉴定时,需要选择专业的医疗机构,并接受医生的指导。
怀孕几个月可以进行DNA亲子鉴定取决于所选取的方法和实验室的要求。一般来说,8周以后可以进行非侵入式的DNA亲子鉴定,而14周以后可以进行侵入式的DNA亲子鉴定。在选择进行DNA亲子鉴定时,需要谨慎考虑各种因素,并选择合适的方法和实验室来确保结果的准确性和可信度。





